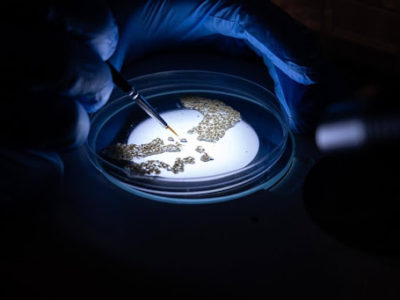

Nicademia Hub, Nigeria’s first hub for creatives has been launched in Lagos, the country’s commercial city of over 18 million people. The new creative hub is located at No. 315 Herbert Macaulay Way, Sabo, Yaba, Lagos which is strategically located at the heart of the tech community in Lagos popularly called ‘Yabacon Valley’.
Nicademia Hub is a work-space for Creatives and Techies, designed for Nigerian Entrepreneurs with the aim of providing the necessary infrastructure needed to leapfrog local Nigerian talents to global standard.
“We have an Amazing Workspace, Recording Studio, Training Room, Meeting Room and Dedicated Office for teams. We also provide unlimited internet and uninterrupted power supply for the startups,” says founder, Valentine Ubalua.
“Nicademia Hub organizes trainings, hackathons, incubation programs, acceleration programs and competitions to create a creative ecosystem that can compete globally with the rest of the world. We are open to collaborations, support and partnerships,” added Ubulua.
Nicademia Hub has work-space available at an affordable rate of N10, 000 per month. “Entrepreneurs get to use all our facilities. “Here is the best part, their monthly subscription gives them 30 Work-space credits which can be shared with their team, staff or anyone. (i.e. their colleagues can use out of their workspace credit without subscribing). They can also use their work-space credit to organize trainings, meetings, interviews, etc. without paying any extra,” said Ubulua.
“We have an amazing Community of Animators, Scriptwriters, Graphic Artists,
Storytellers, Voice Over Artists, Software Developers, Producers etc. that foster
collaboration, teamwork & exchange of services among each other. This in turn
makes it easy for companies, organizations & individuals to locate young talents and provide job & employment opportunities for them,” he added. Nicademia is listed as top 100 most innovative companies to invest in Africa by MyAfricanStartup